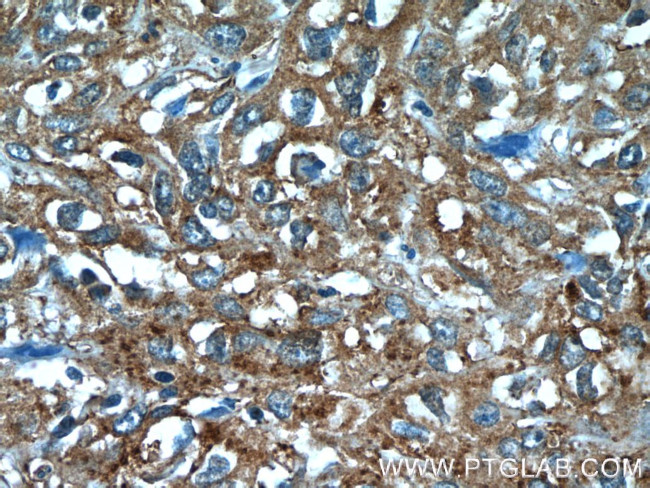
ANKRD57 Antibody in Immunohistochemistry (Paraffin) (IHC (P))

Search
Proteintech
ANKRD57 Polyclonal Antibody
{{$productOrderCtrl.translations['antibody.pdp.commerceCard.promotion.promotions']}}
{{$productOrderCtrl.translations['antibody.pdp.commerceCard.promotion.viewpromo']}}
{{$productOrderCtrl.translations['antibody.pdp.commerceCard.promotion.promocode']}}: {{promo.promoCode}} {{promo.promoTitle}} {{promo.promoDescription}}. {{$productOrderCtrl.translations['antibody.pdp.commerceCard.promotion.learnmore']}}
产品信息
24033-1-AP
种属反应
宿主/亚型
分类
类型
抗原
偶联物
形式
浓度
规格
纯化类型
保存液
内含物
保存条件
运输条件
产品详细信息
Immunogen sequence: MEGPAEWGP EAALGPEAVL RFLAERGGRA LHAELVQHFR GALGGEPEQR ARARAHFKEL VNAVATVRVD PADGAKYVHL KKRFCEGPSE PSGDPPRIQV TAEPEAPDGP AGPEARDRLP DAAAPESLPG QGRELGEGEP PAPAHWPPLS AGARRKNSRR DVQPLPRTPA PGPSEDLELP PHGCEEADRG SSLVGATAQR PARQNLRDLV MGSSPQLKRS VCPGGSSPGS SSGGGRGRGG GDSDSASVAS SSAEEESSGG GSVTLDPLEH AWMLSASDGK WDSLEGLLTC EPGLLVKRDF ITGFTCL (1-306 aa encoded by BC036652)
靶标信息
SOWAHC (Sosondowah Ankyrin Repeat Domain Family Member C) is a Protein Coding gene. An important paralog of this gene is SOWAHA. [GeneCards]
仅用于科研。不用于诊断过程。未经明确授权不得转售。
生物信息学
蛋白别名: ankyrin repeat domain 57; Ankyrin repeat domain-containing protein 57; Ankyrin repeat domain-containing protein SOWAHC; Protein sosondowah homolog C; unnamed protein product
基因别名: ANKRD57; C2orf26; SOWAHC
UniProt ID: (Human) Q53LP3
Entrez Gene ID: (Human) 65124